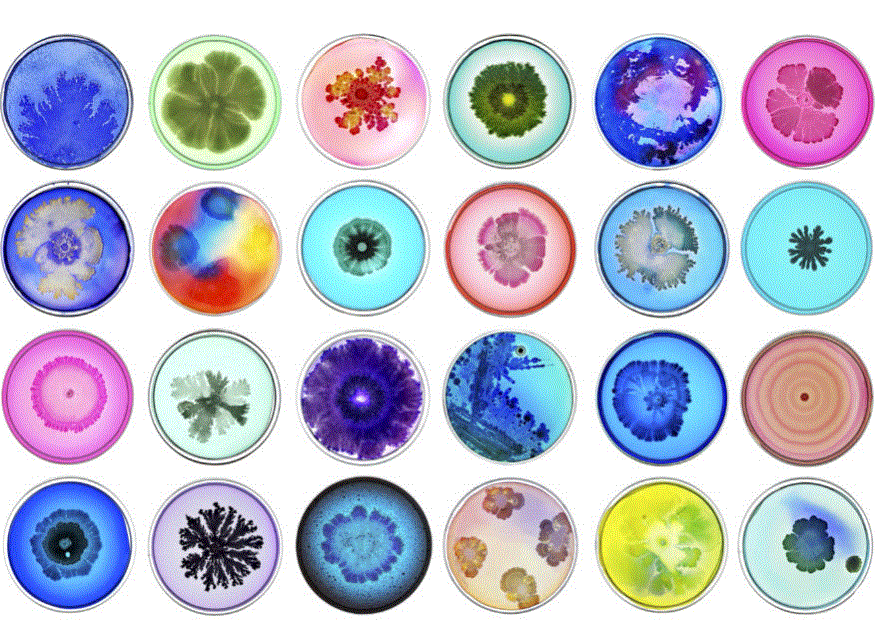

- Beklager. Denne hendelse har allerede funnet sted.
Se inn i det usynlige på Vitenparken
18. juni 2017 - 15. august 2017
Hendelse Navigasjon
18. juni kl 12 åpner utstillingen Se inn i det usynlige!
Med utstillingen ”Se inn i det usynlige” inviterer vi publikum til å dele vår fascinasjon for grenselandet mellom vitenskap, kunst og teknologi.
Utstillingen kan oppleves på Vitenparken i hele sommer. Velkommen!